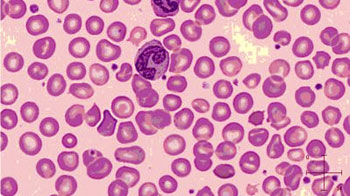

Wie stellt der Arzt einen Eisenmangel oder eine Blutarmut durch Eisenmangel fest?
Krankengeschichte
Unabhängig davon, ob ein Eisenmangel mit oder ohne Anämie besteht, muss der Ursache nachgegangen werden. Die Befragung des Patienten ist ein zentrales Element in der Diagnostik:
- Besteht ein erhöhter Bedarf? – Wachstum, Schwangerschaft, Stillen, Fehlgeburt, Spitzensport?
- Ist die Zufuhr vermindert? – Fleisch- und Fischkonsum, Früchte?; Soja, Tee, Kaffee, Ballaststoffe als Hemmer der Eisenaufnahme?
- Ist die Eisenaufnahme gestört? – Gewichtsabnahme, Blähungen, Durchfall, Darmkrankheiten in der Familie, Operationen, Magen- oder Bauchschmerzen?
- Besteht ein übermässiger Verlust? – Starke Monatsblutung bei Frauen (mehr als 12 Binden pro Periode oder Dauer > 7 Tage), Blutspenden, immer wiederkehrendes Nasenbluten, Blut im Stuhl oder im Auswurf?
Bei Anhaltspunkten für eine Ursache des Eisenmangels, die behandelbar ist, muss eine Abklärung beim entsprechenden Spezialisten erfolgen.
Labordiagnostik
Eisenmangel ohne Blutarmut (Anämie)
Die Diagnose des Eisenmangels ohne Anämie wird durch die Bestimmung des Speicherproteins Ferritin im Blut gestellt. Der Ferritinspiegel korreliert sehr gut mit dem Eisenvorrat im Körper.
Offizielle Grenzwerte, ab wann ein Eisenmangel besteht, gibt es zurzeit noch keine. Weitgehend Einigkeit besteht für folgende Aussagen:
- Ferritin über 50 µg/l: Genügende Eisenreserve
- Ferritin 30 – 50 µg/l: Grauzone, wo ein Eisenmangel mit Beschwerden noch möglich ist
- Ferritin 15 – 30 µg/l: leere oder knappe Eisenspeicher
- Ferritin unter 15 µg/l: Eisenspeicher sind vollständig entleert
Ferritin wird bei Entzündung und Leberzellschädigung vermehrt ins Blut freigesetzt. In diesen Fällen ist das Ferritin kein verlässlicher Messwert für einen Eisenmangel. Dies ist der Grund, warum mit dem Ferritin zusammen immer das CRP (ein Marker für Entzündungen im Körper) und das Leberprotein ALAT bestimmt werden müssen. Ist das CRP oder die ALAT erhöht, kann die Diagnose eines Eisenmangels schwierig werden. Sind die beiden Marker normal, gelten obgenannte Aussagen für den Ferritinwert.
Weitere Befunde eines Eisenmangels sind kleine, nur schwach gefärbte Blutkörperchen (Erythrozyten) im Blutbild als Zeichen der gestörten Blutbildung.
Eisenmangelanämie (Blutarmut durch Eisenmangel)
Die Eisenmangelanämie zeigt sich im roten Blutbild. Die roten Blutkörperchen sind klein, schwach gefärbt und haben unterschiedliche Formen und Grössen:
Leere Eisenspeicher - definiert durch ein sehr tiefes Ferritin – bei reduziertem Hämoglobin bestätigen die Diagnose der Eisenmangelanämie.